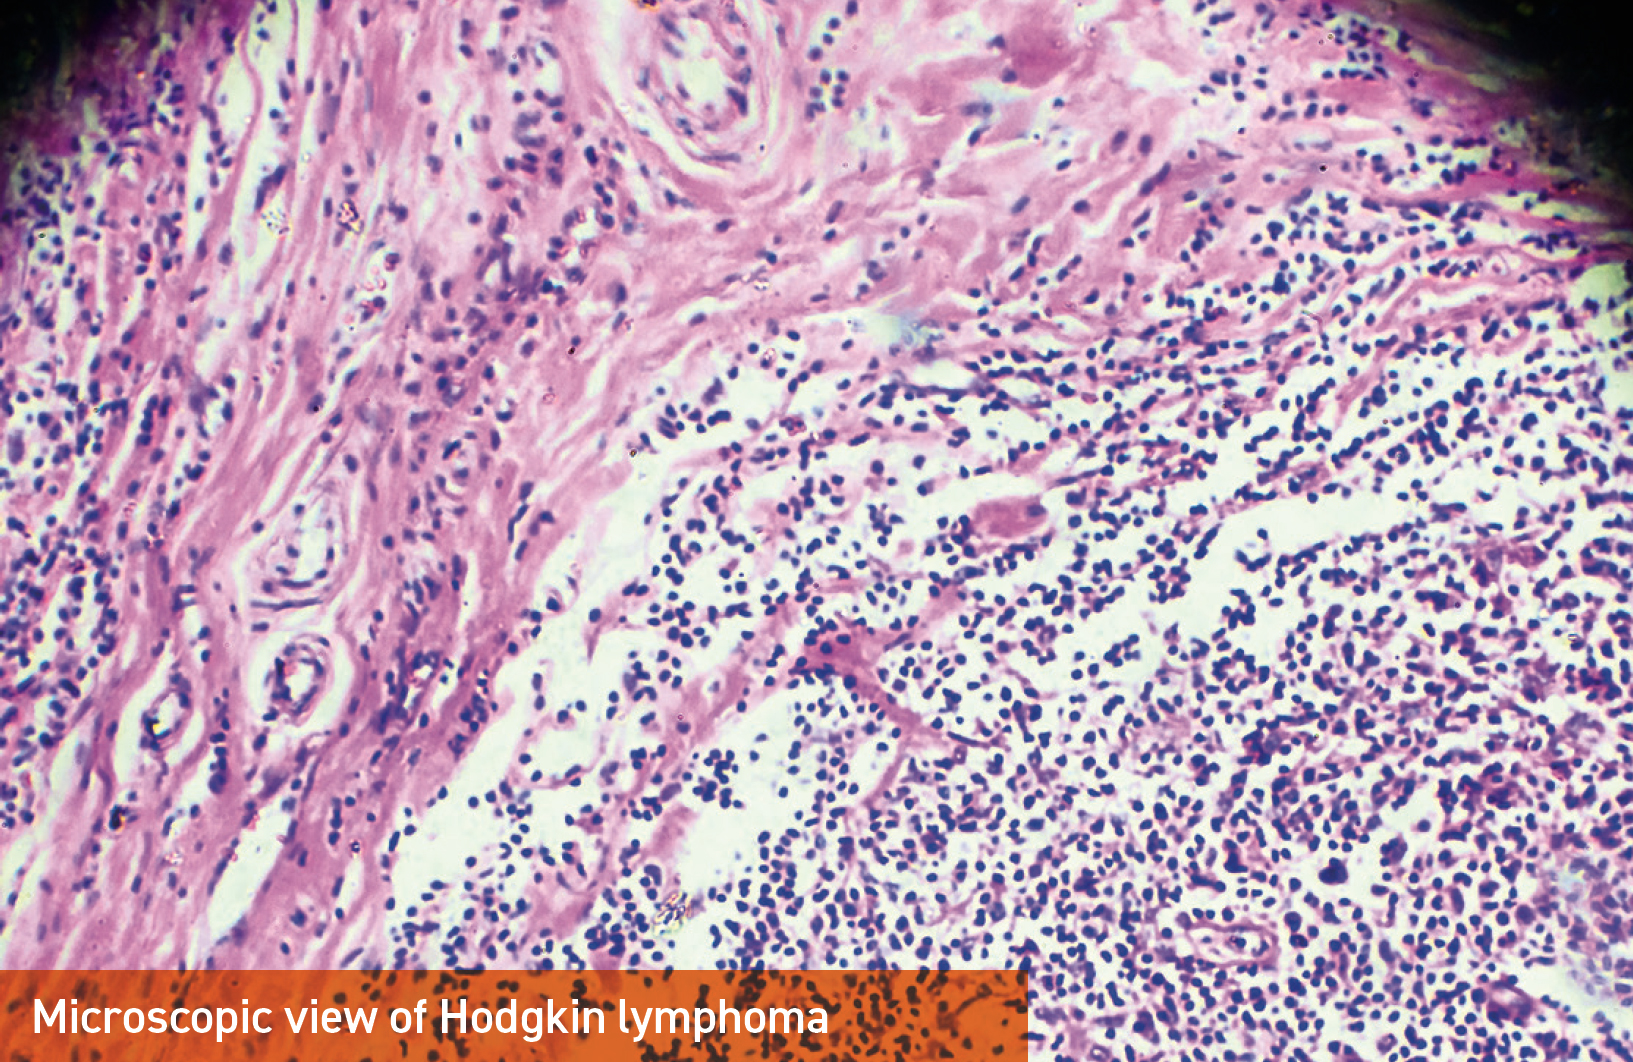
Microscopic view of Hodgkin lymphoma

The results of a Phase 2 study looking at treating relapsed or refractory Hodgkin lymphoma with a new drug protocol were outstanding. They even surprised one of the world’s leading lymphoma experts, Craig Moskowitz, M.D., physician in chief of the Oncology Service Line at Sylvester Comprehensive Cancer Center.
“All the patients treated with our protocol are in remission. These are the best results reported in the literature in the setting of relapsed or refractory Hodgkin lymphoma,” said Dr. Moskowitz, who cowrote the protocol and is senior author of the study, which was published in the Journal of Clinical Oncology. Sylvester hematologist and medical oncologist Georgios Pongas, M.D., also is an author of the study.
Dr. Moskowitz collaborated with colleagues at Memorial Sloan Kettering Cancer Center to study the treatment, which included checkpoint inhibitor pembrolizumab along with chemotherapies gemcitabine, vinorelbine and liposomal doxorubicin. Investigators treated 36 transplant-eligible Hodgkin lymphoma patients who had not responded to frontline medications or relapsed within a year of treatment.